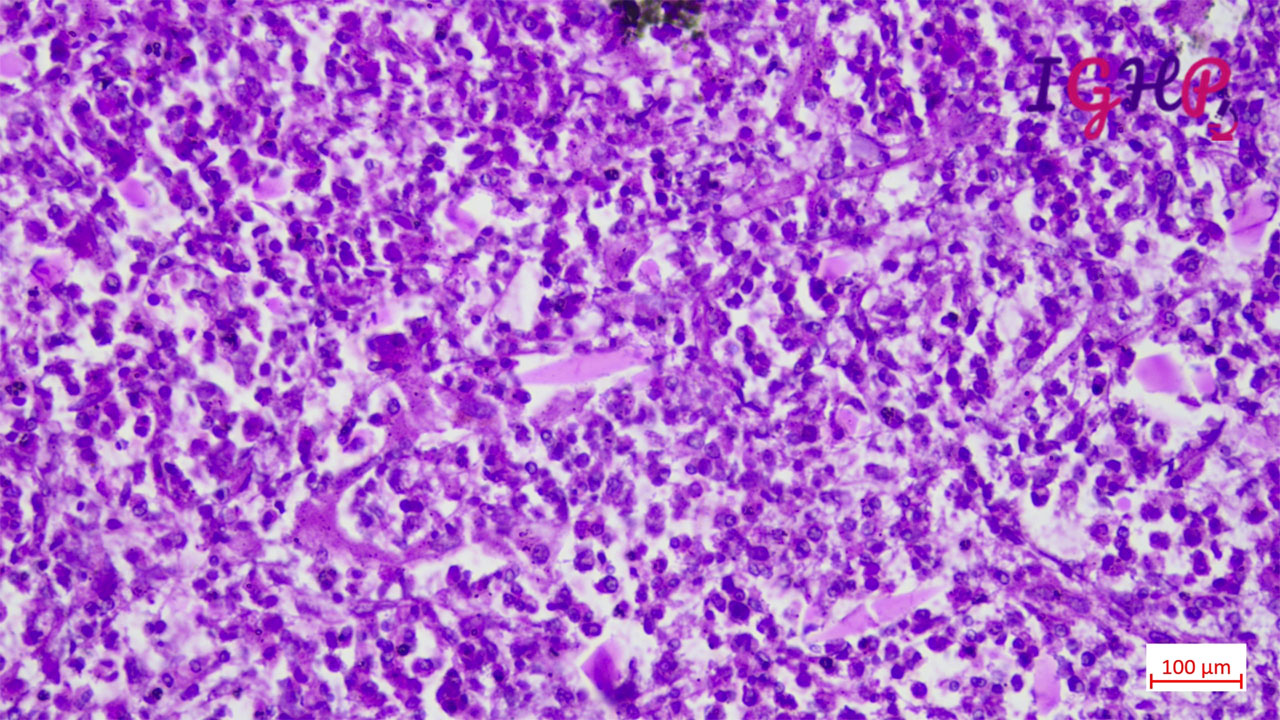

Interesting Case of the Month - (IGHP, ICOM) - September
september 2025
Clinical History-
35-year-old malewithabdominal pain, associated with fever with chills off and on and nausea and vomiting. AFP- normal, Serology- for viral markers negative. CBC showed eosinophilia.
From the images below identify the likely disease?
Radiology-
USG-
Liver showed multiple small lesions largest measuring 3.0 x 2.8 cm.
Microscopic Images-
Microscopic examination showed eosinophilic abscess with multiple cholesterol clefts.
Special Stain Performed--
PAS, MT and Orcein stains performed showed presence of CharcotLayden crystals.
Diagnosis-
Eosinophilic granuloma
Granulomatous Hepatitis
Cholangiocarcinoma
Schistosomiasis